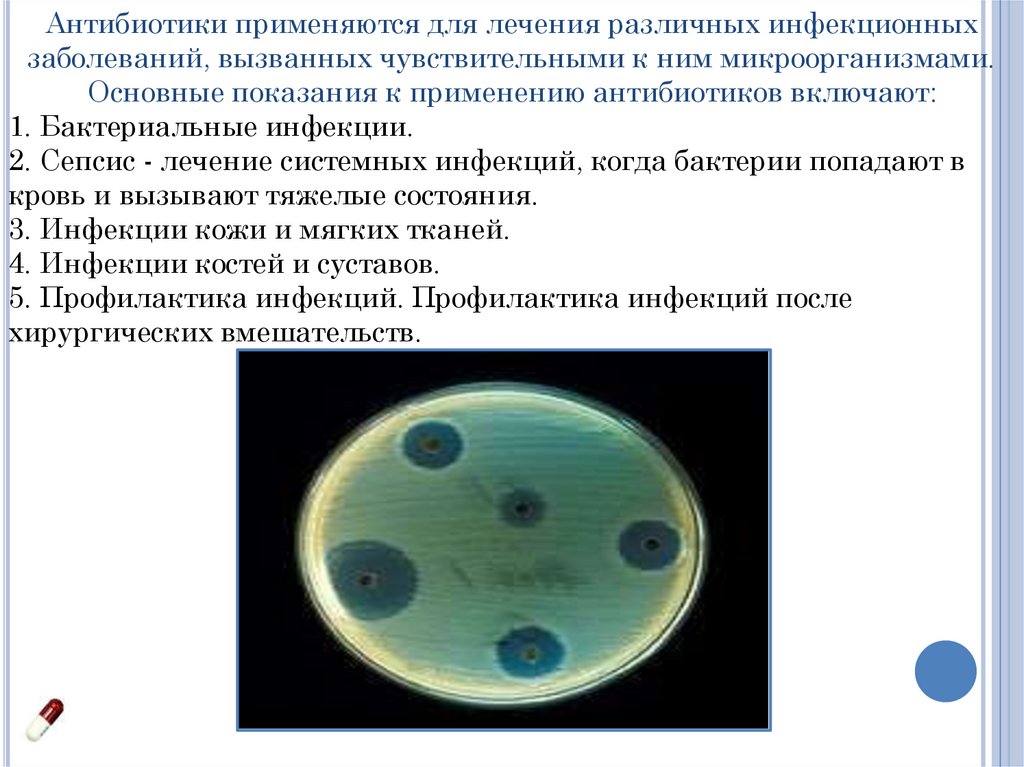

Similar presentations:
Антибиотики - мощное оружие
1.
Государственное автономное профессиональное образовательное учреждение«Липецкий медицинский колледж»
Выполнила: Денисова Кристина
Александровна
Студентка группы 1к1фарм
Специальность 33.02.01 Фармация
Руководитель: Крупина Тамара Алексеевна
2.
Антибиотики представляют собой одну изактуальных находок XX века, изменившую подход к
лечению инфекционных заболеваний и спасшую
миллионы жизней. Эти вещества, обладающие
способностью подавлять рост и размножение
бактерий, стали основным инструментом в
борьбе с инфекциями, которые ранее считались
смертельными.
Цель данного проекта:
- это изучить антибиотики как мощное
оружие в борьбе различными заболеваниями.
Задачи:
1. Изучить историю открытия и развития
антибиотиков.
2. Классифицировать антибиотики.
3. Исследовать проблему
антибиотикорезистентности.
4. Рассмотреть также ряд побочных
эффектов от антибиотиков.
5. Разработать рекомендации по
рациональному использованию антибиотиков.
6. Подвести выводы о проделанной работе.
3.
Пенициллин —первый антибиотик,
полученный на основе
продуктов
жизнедеятельности
микроорганизмов. Он был
обнаружен в 1928 году
Александром Флемингом в
культуре плесневых штамма
грибков Penicillium
Notatum,на основе
случайного открытия, что
попадание в культуру
бактерий плесневого грибка
из внешней среды оказывает
бактерицидное действие на
культуру.
4.
(от др-греч. ἀντί — anti — против, βίος —bios — жизнь) — вещества природного
или полусинтетического происхождения,
подавляющие рост живых клеток, чаще
всего прокариотических или простейших.
5.
1. По происхождению:- Природные антибиотики.
Вырабатываются
микроорганизмами.
- Полусинтетические
антибиотики. Измененные
природные антибиотики,
которые были химически
модифицированы для
улучшения их свойств.
- Синтетические антибиотики.
Созданы искусственно, не
встречаются в природе.
Например:
2. По механизму действия:
- Бактерицидные антибиотики.
Убивают бактерии, нарушая
процессы, необходимые для их
жизни. Примеры:
- Бактериостатические
антибиотики. Останавливают
рост и размножение бактерий,
позволяя иммунной системе
человека справляться с
инфекцией.
6.
3. По химической структуре:Антибиотики также
классифицируются по их
химической структуре.
Некоторые из основных классов
включают:
- Бета-лактамы: антибиотики,
имеющие бета-лактамное кольцо,
которое является ключевым для
их действия. Классы включают
пенициллины и цефалоспорины.
- Макролиды: обладают
макролидным кольцом.
Примеры: Эритромицин,
Азитромицин.
- Тетрациклины: имеют
четырёхкольцевую структуру,
например, Тетрациклин,
Доксциклин.
- Аминогликозиды: основаны на
аминокислотах, например,
Гентамицин, Неомицин.
- Фторхинолоны: содержат фтор,
например, Ципрофлоксацин,
Левофлоксацин.
7.
Антибиотики применяются для лечения различных инфекционныхзаболеваний, вызванных чувствительными к ним микроорганизмами.
Основные показания к применению антибиотиков включают:
1. Бактериальные инфекции.
2. Сепсис - лечение системных инфекций, когда бактерии попадают в
кровь и вызывают тяжелые состояния.
3. Инфекции кожи и мягких тканей.
4. Инфекции костей и суставов.
5. Профилактика инфекций. Профилактика инфекций после
хирургических вмешательств.
8.
Использование антибиотиков, несмотря на их значимость влечении инфекционных заболеваний, связано с рядом серьезных
проблем, которые могут негативно сказаться на здоровье
населения и системе здравоохранения в целом. Основные
проблемы включают:
1. Антибиотикорезистентность - это способность бактерий
вырабатывать устойчивость к действию антибиотиков, что делает
лечение инфекций менее эффективным.
Причины:
- Чрезмерное и неправильное использование антибиотиков,
включая самолечение и неполное завершение курсов лечения.
- Использование антибиотиков в сельском хозяйстве для
стимуляции роста животных и профилактики заболеваний.
- Неправильная диагностика инфекций, когда антибиотики
назначаются при вирусных заболеваниях, где они неэффективны.
- Последствия: Увеличение числа инфекций, которые трудно
поддаются лечению, рост заболеваемости и смертности,
увеличение затрат на здравоохранение.
2. Побочные эффекты
- Аллергические реакции.
- Токсичность.
9.
Правильное использование антибиотиков критически важнодля их эффективности и для борьбы с растущей проблемой
антибиотикорезистентности. К основным рекомендациям по
рациональному применению антибиотиков относят:
1. Используйте антибиотики только по назначению врача.
2. Соблюдайте назначенный режим. Строго соблюдайте
назначенные врачом дозировку и продолжительность курса
лечения. Неполное лечение может привести к восстановлению
инфекции и развитию устойчивости у бактерий.
3. Не принимайте антибиотики без назначения.
4. Информируйте врача о медицинской истории. При обращении к
врачу расскажите о своих предыдущих инфекциях, аллергиях.
5. Следите за побочными эффектами.
6. Оценка необходимости антибиотиков. Вместе с врачом
обсуждайте необходимость назначения антибиотиков, рассматривая
все возможные варианты лечения и альтернативах.
10.
Антибиотики стали одним из величайшихдостижений медицины, изменив подход к
лечению инфекционных заболеваний и
спасая миллионы жизней на протяжении
более чем столетия. Они
продемонстрировали свою эффективность
в борьбе с бактериальными инфекциями,
обеспечивая значительное снижение
заболеваемости и смертности.
Однако, с увеличением применения
антибиотиков и, соответственно, их
чрезмерным использованием возникла
одна из самых серьезных угроз для
общественного здоровья –
антибиотикорезистентность. Этот
феномен ставит под сомнение
эффективность антибиотиков и требует
от нас серьезного пересмотра подходов к их

medicine
medicine








